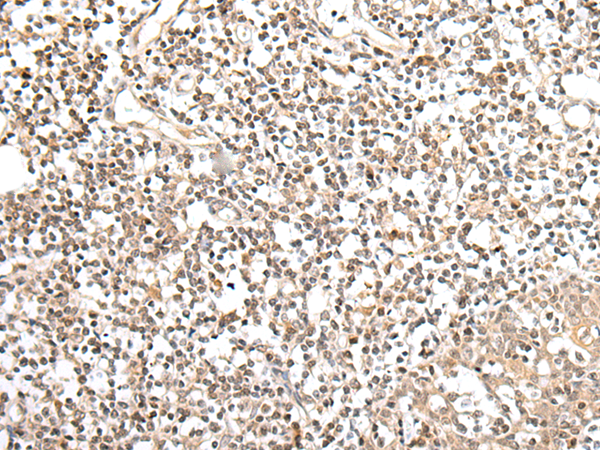
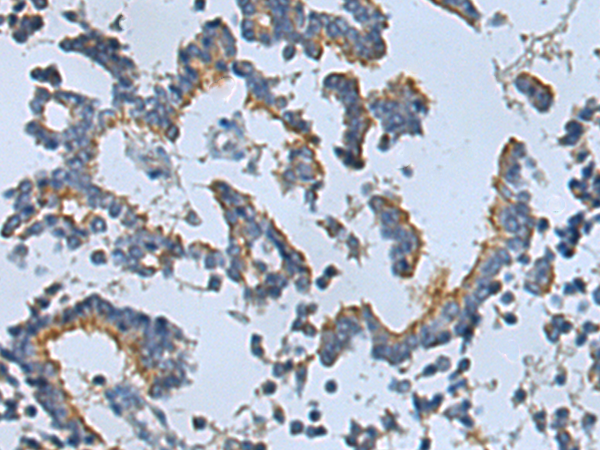

-
分类: 科研抗体货号: P05757别名: AT591; CMT1D; CMT4E; KROX20应用: WB,IHC反应种属: Human, Mouse, Rat
-
分类: 科研抗体货号: P05706别名: MT2; FGQTL2; MEL-1B-R应用: IHC反应种属: Human
-
分类: 科研抗体货号: P05822别名: IFCR; MGA1; gp280应用: IHC反应种属: Human, Mouse
-
分类: 科研抗体货号: P05700别名: FH; FHC; LDLCQ2应用: IHC反应种属: Human, Mouse, Rat
-
分类: 科研抗体货号: P05756别名: E2F-3应用: IHC反应种属: Human, Mouse
-
分类: 科研抗体货号: P05699别名: IBP2; IGF-BP53应用: IHC反应种属: Human, Mouse, Rat
-
分类: 科研抗体货号: P05820别名:应用: WB,IHC反应种属: Human, Mouse, Rat
-
分类: 科研抗体货号: P05755别名: E2F-8应用: WB,IHC反应种属: Human, Rat
-
分类: 科研抗体货号: P05816别名: STMP; IPCA1; PUMPCn; STAMP1; PCANAP1应用: WB,IHC反应种属: Human, Mouse, Rat
-
分类: 科研抗体货号: P05754别名: 2410091M23Rik应用: WB,IHC反应种属: Human

鄂公网安备42018502007531号
鄂公网安备42018502007531号

